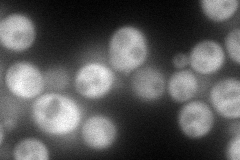
YBR166C
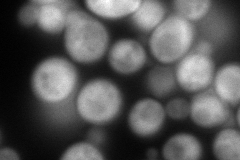
YBR166C
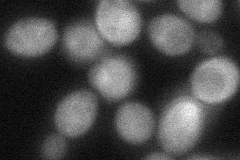
YBR166C
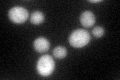
YBR166C
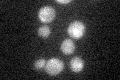
YBR166C

View description
Prephenate dehydrogenase involved in tyrosine biosynthesis, expression is dependent on phenylalanine levels
Localization:
Intensity:
Fold change:
Significance:
-
C’ GFP library in SD

cytosol43.07 -
N' NOP1pr-GFP in SD
cytosol117.929 -
N' TEF2pr-mCherry in SD
cytosol202.772 -
N' NATIVEpr-GFP in SD

cytosol45.1284 -
N' TEF2pr-VC and Cyto-VN in SD
cytosol48.6968 -
C’ GFP library in SD+DTT
cytosol37.90.87No -
C’ GFP library in SD+H2O2

cytosol44.861.04No -
C’ GFP library in Starvation Media
cytosol26.460.61No -
C’ GFP library on the background of Pup2-DaMP

cytosol -
C’ GFP library on the background of CCT mutant

cytosol45.29921.0515No
